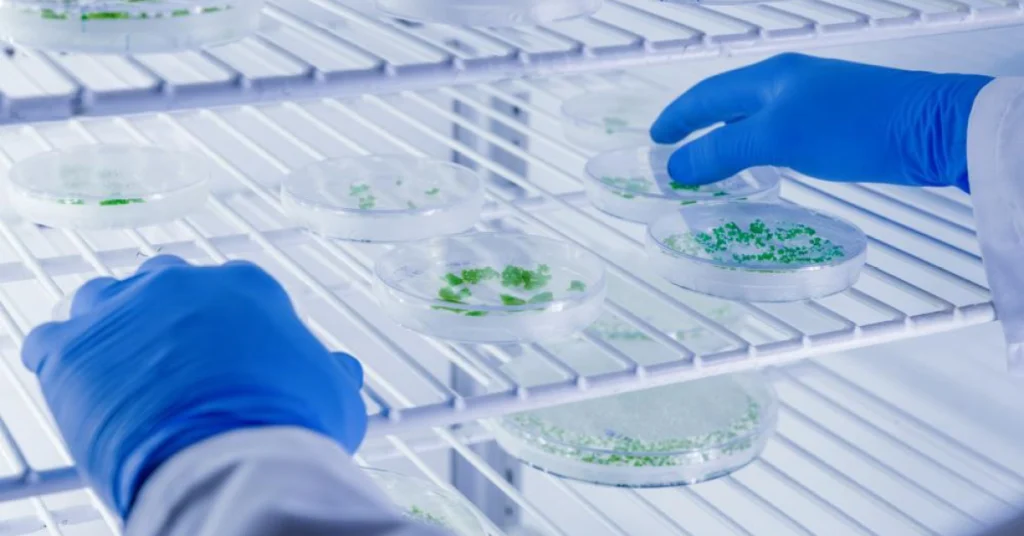

Commercial Refrigeration Service and Repairs
Adelaide’s Leading Commercial Refrigeration Repairs Specialist
Reliable commercial refrigeration is critical for businesses handling food, beverages, medical supplies, or perishable goods. Efficient refrigeration ensures product safety, reduces spoilage, and keeps your operations running smoothly, maintaining compliance and customer trust.
At BOSSY’s, we provide expert commercial refrigeration repairs across Adelaide and South Australia. With decades of experience, our fully in-house team specialises in servicing, repairing, and maintaining fridges, freezers, cool rooms, and specialised refrigeration systems tailored to the unique requirements of each commercial environment.
Our long-standing relationships with suppliers allow us to source high-quality refrigeration parts and components at competitive prices, providing cost-effective solutions without compromising reliability or efficiency. We also offer customised maintenance and monitoring plans to suit every business’s needs and budget.
Our Commercial Refrigeration Repair Services

Maintenance: A Proactive Approach
We firmly believe that prevention is better than cure.
BOSSY’s can create a tailored commercial refrigeration service plan that suits your business needs and budget, keeping your equipment running smoothly all year round and minimising unexpected downtime.
Stay Ahead with Advanced Monitoring
By installing a temperature and alarm monitoring system, we can immediately be advised of any issues and attend to them promptly, including conducting commercial fridge repairs if necessary.
We are adept at both retrofitting existing installations and seamlessly integrating these systems with new ones.


Upgrade with Confidence
If your equipment is outdated or inefficient, we provide expert guidance on replacements.
From walk-in cold rooms to specialised medical refrigerators, our comprehensive solutions are designed for maximum reliability, energy efficiency, and long-term performance.
Swift Repairs – Anytime, Anywhere
Breakdowns don’t wait for business hours. Our skilled mobile team is available 24/7, 365 days a year, to carry out fast, effective commercial refrigeration repairs across Adelaide, keeping your operations running with minimal disruption.

Commercial Refrigeration Systems We Service
We provide expert commercial refrigeration servicing and repairs across Adelaide for a wide range of systems, catering to businesses of all sizes and industries.

Kitchen and Catering
- Stainless Steel Commercial Refrigerators
- Commercial Freezers
- Catering Fridges and Freezers
- Commercial Cool Rooms

Beverage and Display
- Ice Machines
- Post Mix Coolers
- Beer Systems and Bottle Cabinets
- Water Coolers
Industrial and Specialty
- Medical Fridges
- Hot Rooms and Industrial Cold Stores
How We Handle Commercial Refrigeration Repairs
1. Consultation and Site Assessment
We evaluate your equipment, operational requirements, and storage needs to recommend the best solution for you.
2. Transparent Quotation
Receive a detailed, obligation-free quote outlining repair, maintenance, or replacement options.
3. Approval and Scheduling
Once approved, we coordinate with you to minimise disruption to your operations.
4. Professional Repair and Service
All work is performed in-house by qualified BOSSY’s technicians, ensuring full compliance with Australian standards.
5. Testing and Handover
Each repair or maintenance task is thoroughly tested before handover to confirm optimal performance.
6. Ongoing Maintenance and Monitoring
We offer scheduled maintenance programs and advanced monitoring to prevent breakdowns and maximise equipment life.
Industries We Serve
Our experienced team delivers commercial refrigeration repair in Adelaide across multiple sectors:
Restaurants and Cafés
Pubs, Clubs, Hotels, and Bars
Fast Food and Takeaway Venues
Wineries and Cellars
Service Stations and Convenience Stores
Sporting Facilities and Event Venues
Commercial Kitchens and Production Facilities
Aged Care, Healthcare, and Education Sectors
Reliable Commercial Refrigeration. Professionally Serviced.
Expert commercial refrigeration repair for Adelaide businesses by South Australia’s trusted refrigeration experts.
Available 24/7 for emergency commercial refrigeration repairs.
Sustainability and Energy Efficiency
At BOSSY’s, environmental responsibility is part of how we do business. We stay up to date with global refrigeration trends, evolving technologies, and local regulations – particularly those relating to refrigerant management and environmental compliance.
We offer expert guidance on selecting low-impact refrigerants and designing energy-efficient refrigeration systems that reduce your carbon footprint and operating costs. Our advanced control solutions also provide automated monitoring of temperature and humidity, helping you protect stock, reduce waste, and maintain compliance with ease.











Why Choose BOSSY’s for Catering Fridges and Freezers
Decades of Industry Experience
With over 30 years of expertise, we provide reliable commercial refrigeration services to Adelaide’s wide range of businesses, from hospitality to healthcare.
Comprehensive End-to-End Service
From design and supply to installation, maintenance, and emergency repairs, every service is handled in-house by our skilled team.
Access to Leading Brands
We work with trusted global refrigeration brands, delivering high-quality, cost-effective solutions that suit your budget without compromising performance.
Technical Proficiency
Our fully qualified technicians are experienced in servicing, repairing, and maintaining all types of commercial refrigeration systems.
Customer Satisfaction
As a South Australian family business, we place customer satisfaction at the heart of everything we do, maintaining the highest standards of quality, reliability, and accountability.



FAQs
How fast can you respond to an emergency refrigeration breakdown?
We offer 24/7 mobile commercial fridge repair in Adelaide, ensuring rapid response and minimal downtime for your business.
How long does a commercial refrigeration repair take?
Repair times vary depending on the type and complexity of the system. Our technicians work efficiently to get your equipment back up and running as quickly as possible.
Are your repairs compliant with Australian Standards?
Yes. All repairs are performed by licensed BOSSY’s technicians and fully comply with Australian Standards, workplace safety regulations, and environmental requirements.
Do you use subcontractors?
No. All commercial refrigeration repair work in Adelaide is carried out exclusively by our in-house team, ensuring consistent quality and accountability.
Will repairs disrupt business operations?
We carefully plan and schedule work to minimise downtime, allowing your business to continue operating safely and efficiently during repairs.
Do you install monitoring systems?
Yes. We can install temperature and alarm monitoring systems to detect issues early, enabling us to respond immediately and prevent costly breakdowns.
What maintenance is required for a commercial refrigeration system?
We generally recommend servicing your refrigeration systems at least once, ideally twice, per year to maintain maximum efficiency and reduce energy costs.
We offer a fully programmed commercial refrigeration maintenance service to ensure you never miss a service. Our team can also assess your current system, perform testing, and recommend efficiency upgrades tailored to your business.
Maintain Your Cool with BOSSY’s
Protect your products, prevent costly spoilage, and maintain your business reputation with Adelaide’s trusted commercial refrigeration repair specialists. Speak with our team today for a no-obligation quote on your next project.
Looking for Reliable Commercial Refrigeration Repairs?
Contact Us Now!
Phone: 08 8177 0761
Email: sales@bossys.au
Address: BOSSY’S
Unit 5, 4 Iris Street
Melrose Park, SA 5039
